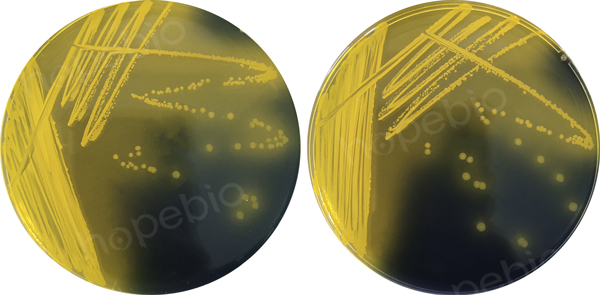
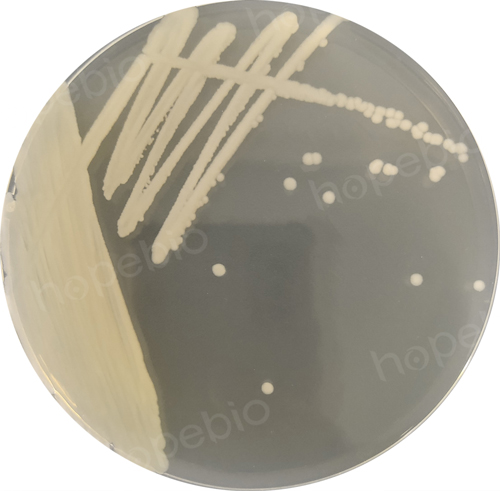

海博微信公众号
海博微信公众号
 海博天猫旗舰店
海博天猫旗舰店


 海博微信公众号
海博微信公众号
 海博天猫旗舰店
海博天猫旗舰店




一、参考标准
《GB4789.44-2020食品安全国家标准 食品微生物学检验 创伤弧菌检验》点击下载
二、简介
1、生物学特征:创伤弧菌(Vibrio vulnificus)是一种海洋弧菌。形态:革兰氏阴性弧菌,在液体培养基中菌体大小为0.7*2-3 μm,稍弯曲;在固体培养基中呈多样性,有极端单鞭毛。培养特性:营养要求一般,最适生长温度为30℃,兼性厌氧;在无NaCl及超过8%NaCl的培养基中不生长,可在0.5%NaCl及3%NaCl的蛋白胨水中生长,在含6%NaCl的蛋白胨水中生长良好。
2、流行病学特点:创伤弧菌广泛分布在海水中,可从牡蛎等海产品中分离得到。本菌主要通过伤口接触海水造成感染,也可经口感染。经伤口感染时可导致蜂窝织炎及骨髓炎等多种炎症,经口感染时常迅速导致菌血症或败血症。感染本菌后如不及时治疗,病死率很高。
三、检验程序

四、操作步骤
1.样品制备
以无菌操作取处理后的样品25g,加入蛋白胨-氯化钠-纤维素二糖-多黏菌素E(PNCC)增菌液225mL,用均质器均质2min,充分混匀制备成1:10的样品匀液。
注意:新鲜样品采集后应于3h内完成检验,若不能在规定时间内完成,则将样品置于7℃-10℃条件下保存(因创伤弧菌在4℃条件下极易形成活而不可培养的状态,因此样品勿放4℃条件下),并尽可能在24h内完成检验;冷冻样品应在不超过45℃的温热条件下解冻,解冻时间不超过15min。
2.增菌
将制备的1:10样品匀液于36℃±1℃培养18h±1h。结果如图2所示:

图2 PNCC增菌液培养结果
3.PCR检测
4.分离
用10μL接种环在距离PNCC增菌液的液面下1cm沾取一环增菌液,分别划线接种于纤维素二糖-多黏菌素E(CC)和改良纤维二糖-多黏菌素B-多黏菌素E(mCPC)琼脂培养基平板,于36℃±1℃条件下培养18h±1h。
典型的创伤弧菌可以发酵纤维二糖产酸使培养基变黄,所以在CC和mCPC平板上的形态为:圆形、扁平,光照下呈透明或中心不透明但边缘透明的黄色至橘黄色菌落,菌落直径1mm~2mm,菌落周围可出现(或不出现)黄色晕圈。结果如图3所示:
图3 创伤弧菌CICC 10383在CC和mCPC琼脂培养基平板上的培养结果
5.分纯培养
从CC平板和mCPC平板上各挑取至少5个创伤弧菌可疑菌落(少于5个时全选),分别接种于3%氯化钠胰蛋白胨大豆琼脂平板,36℃±1℃培养18h±1h后用于后续鉴定。
创伤弧菌在3%氯化钠胰蛋白胨大豆琼脂平板上的菌落形态为:圆形、乳白色、湿润、隆起、直径1mm~2mm。结果如图4所示:
图4 创伤弧菌CICC 10383在3%氯化钠胰蛋白胨大豆琼脂平板上的培养结果
6.鉴定
创伤弧菌可采用菌落特征结合生化特性或PCR方法进行鉴定。
6.1 菌落特征及生化特性
6.1.1 初步鉴定
该步骤用于创伤弧菌的初步鉴定,进行以下4项鉴定实验时,挑取的菌落应来自分纯后的同一个单菌落。
(1)革兰氏染色镜检:从分纯培养的3%氯化钠胰蛋白胨大豆琼脂平板上挑取创伤弧菌疑似菌落进行革兰氏染色镜检。
创伤弧菌为革兰氏阴性,显微镜下菌体为棒状、弧状、卵圆状等多种形态,无芽胞,如图5所示:

图5 革兰氏染色结果
(2)氧化酶试验:用接种环挑取从分纯培养的3%氯化钠胰蛋白胨大豆琼脂平板上挑取创伤弧菌疑似菌落适量涂在蒸馏水润湿的氧化酶试纸上,在10 s内变为蓝色或蓝紫色为阳性,2 min内不变色为阴性。
创伤弧菌在氧化酶试纸上显蓝色,为阳性。结果如图6所示:

图6 氧化酶试验结果
注:a:创伤弧菌CICC 10383;b:大肠埃希氏菌ATCC 25922
(3)三糖铁试验:用接种针从分纯培养的3%氯化钠胰蛋白胨大豆琼脂平板上挑取创伤弧菌疑似菌落适量,转种于3%氯化钠三糖铁琼脂斜面并穿刺底层(注意接种针不要触及试管底部),36℃±1℃培养24h,观察结果。
创伤弧菌可以发酵葡萄糖产酸不产气,使斜面变黄,但因接触空气而氧化,加之细菌生长利用培养基中含氮物质,生成碱性产物,故斜面后来又变红。底部由于厌氧状态,酸类不被氧化,仍保持黄色。所以在3%氯化钠三糖铁琼脂斜面中生长时试管底层变黄,无气泡,斜面颜色不变黄。结果如图7所示:

图7 3%氯化钠三糖铁琼脂培养结果
注:a:空白对照;b:创伤弧菌CICC 10383
(4)嗜盐性试验:用接种针从分纯培养的3%氯化钠胰蛋白胨大豆琼脂平板上挑取创伤弧菌疑似菌落分别接种于含有0%、3%、6%、8%、和10%氯化钠的胰蛋白胨水中,36℃±1℃培养24h,观察液体的混浊情况。
创伤弧菌在含有0%、8%、和10%氯化钠的胰蛋白胨水中不生长或微弱生长,胰蛋白胨水澄清透亮或稍混浊,而在3%和6%氯化钠的胰蛋白胨水中生长旺盛,胰蛋白胨水混浊。结果如图8所示:

图8 胰蛋白胨水培养结果
6.1.2 确证实验
将初步鉴定为创伤弧菌的疑似菌落接种在3%氯化钠胰蛋白胨大豆琼脂平板上,36℃±1℃培养18h±1h后,取纯培养物分别接种于含3%氯化钠的赖氨酸脱酸酶试验培养基和MR-VP培养基中,36℃±1℃培养24h~48h后观察结果;
另取少许纯培养物接种于3%氯化钠三糖铁琼脂斜面,36℃±1℃培养18h后用于ONPG试验。结果如图9所示:

图9 确证试验结果
注:a:对照;b:创伤弧菌CICC 10383
7.结果与报告
根据菌落特征、生化特征或PCR鉴定结果,报告25g样品中检出或未检出创伤弧菌。
相关标准:
GB 4789.44-2020 食品微生物学检验 创伤弧菌检验 点击下载
相关产品:
蛋白胨-氯化钠-纤维二糖-多粘菌素E(PNCC)增菌液-点击查看产品详情
注:本文属海博生物原创,未经允许不得转载。



